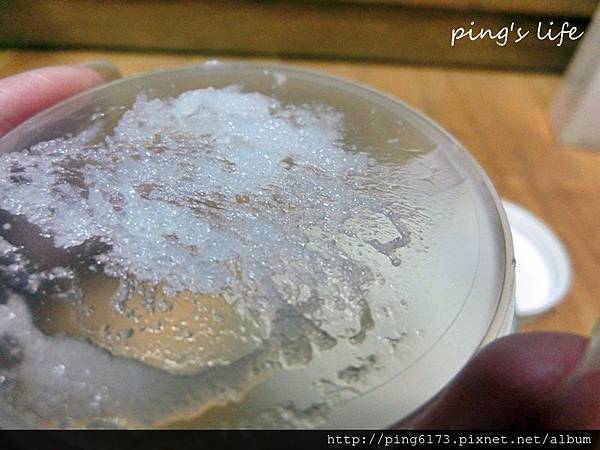

上次高雄10/10看Omorovicza黃金系列時,有聽說有新品會上市
那時沒買這牌子主要跟我原本幻想的有落差
新品叫藍鑽Blue Diamond
以下官網抓來的訊息可以參考
藍鑽系列為英國倫敦Harrods奢華百貨首售的暢銷系列
以最新成分研發,由內而外為肌膚挹注源源生機喚醒肌膚晶澤光耀
新品系列包含藍鑽集中精華、藍鑽頂級乳霜與藍鑽亮采面膜
皆含有主要藍 鑽三星成分:
賦活晶鑽胜肽、阿拉伯半乳聚醣、以及胺基酸複合銅
能使肌膚維持健康活力,告別暗沈,帶來緊緻光采
運用Omorovicza獨創『礦泉護膚 導入科技TM』
將大自然珍貴有效成分以階段性滲入肌膚底層
充分提升保養吸收力,使肌膚呈現最佳膚態
沒幾天就收到台北認識專櫃友人自動寄來的試用包
不過由於最近太多面霜test,尚在排隊中
聽說是比黃金不黏膩質地清爽些
也就是上回被我打槍其中原因
其實這包也是精華後來發現公司標籤貼錯
乳白色的「藍鑽亮采面膜」展現青春肌膚的內蘊光澤
乳糖酸與天然果酸,造就不刺激無致敏的煥膚產品,溫和幫助細胞代謝
同時維持皮脂平衡狀態,讓肌膚更潔淨、晶耀、緊緻
角質溶解酵素能溫和提升細胞代謝率,並煥生新肌
生物相容銅化合物重建肌膚彈性
猶如喀什米爾羊毛般的柔滑觸感,重現年輕肌膚的水潤光澤
賦活晶鑽胜肽能減緩DNA老化,帶來細緻膚質
胺基酸複合銅協同膠原蛋白作用
創新玻尿酸立即提供滿足肌膚所需的豐盈水份及緊緻感
再來說一下換貨
上回至高雄就是要買EVELOM晨間煥采潔顏乳
結果卻帶回nb美白卸妝凝露
還好兩品都有挖試用回來,還是喜歡EVELOM
其實我買東西不會很囉唆,不喜歡頂多丟給老媽接收
但真的非常受不了nb美白卸妝洗後滑滑的感覺
記得是跟小姐說要早上洗的滋潤款不要泡泡
才挑EVELOM晨間煥采潔顏乳滴
如果是自己踩雷那就算ㄌ願賭服輸..
自己腦波也弱,每次洗完搞得心情都不是很美
才跟櫃姐說要換貨,懶得下去就用配送
換了兩條還有餘額@@
瓶蓋設計
真的不會油洗完很舒爽,毛孔很乾淨味道我又超愛
氣味是會影響整天心情的溜
CHRISTOPHE ROBIN海鹽舒緩頭皮潔淨霜
上次在hope拿試用品回來有喜歡對頭皮癢痘子有效
洗兒子臭臭油垢味也不錯
當時缺貨沒買到,就補差額來一罐
海鹽顆粒屢試不爽它真的會溶不見呀
今天收到貨小姐也有附試用包
欲望清單是左下黃色的眼霜
面霜我應該會選nb鑽石系列或蜂牲肽吧??
早上擦了蜂牲肽面霜很喜歡很緊,不油膩
可以來代替貴33的極製日乳??
藍鑽面霜和精華這幾天排到了
質地比黃金優是清爽的,擦ㄌ臉有亮度和緊
不過夏天再熱些擦,最近續航力不太夠
和緊實拉提效果比還是r牌蜂牲肽強
sj面膜雖然超讚,霜和既有rv重覆都含酸類不會買
藍鑽剛拿到所以暫時是這樣會不會改不知道
至於精華我還是會沿用肌膚之鑰和香緹卡其中品項
nb的美白精華和霜個人用不太習慣,精華對我來說太強了
但是美白面膜有喜歡,氣味和鑽石相同蠻舒服
和sj不同前者是乾淨透亮,nb是濕潤光感的白
elemis是試用緊緻面膜應該不會帶
味道個人不愛,效果要長期試才有感覺吧
sj比較立即性明亮膚色

留言列表
留言列表
